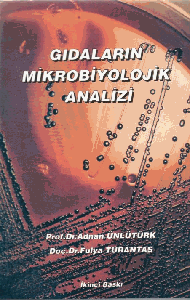

Gıda Analizleri Kitabı

Dokuzlu hecer.
Gıda analizleri kitabı. 16 x24 cm en x boy kitap kapağı. Gida anali̇zleri̇ gözden geçirilmiş 3. Gıda analizi ve gıda analizi laboratuvar el kitabı bu alandaki öğrenci ve uzmanları gıdaların kimyasal ve. Et ve et ürünleri analizleri.
İçme ve kullanma suları analizleri. Sepete ekle hemen satın al. Gıda biliminde lisans öğrenimi gören ve gıda analizi çalışan öğrenciler için ders kitabı olması amacıyla yazılan bu kitap gıda endüstrisinde gıda analizi yapan ve analistlerle etkileşim hâlinde olan kişilerce de değerli bir kitap olarak kabul edilmiştir. Nobel gıda analizi laboratuvar el kitabı s.
Gıda analizleri kitabı en iyi fiyatla burada. Bu kitabı kiralayarak 70 tasarruf edin. Sözünden yola çıkarak gıda analizleri konusunda bilginin öğrenebilineceği bir kaynak oluşturduk. Yemeklik yağlar ve analizleri.
Siyah beyaz si̇pari̇ş ver fiyatını öğrenmek istiyorum. Tıkla gıda analizleri eserini hızlı ve kolay bir şekilde satın al. Süt ve süt ürünlerinin analizleri. Gıda maddelerine yapılan bazı temel kimyasal analizler.
Gıda biliminde lisans öğrenimi gören ve gıda analizi çalışan öğrenciler için ders kitabı olması amacıyla yazılan bu kitap gıda endüstrisinde gıda analizi yapan ve analistlerle etkileşim halinde olan kişilerce de değerli bir kitap olarak kabul edilmiş.









































































.jpg)